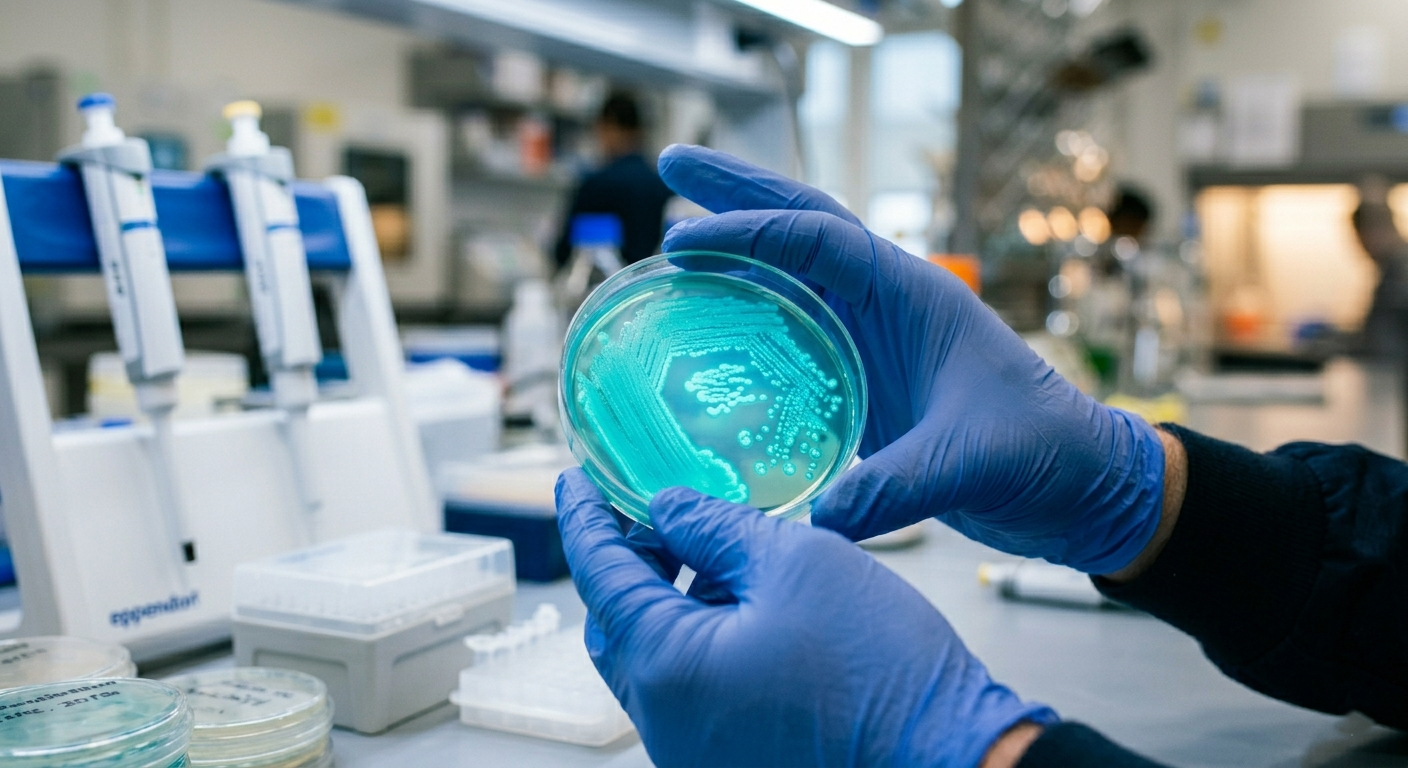
Knowledge for Growth 2026

Knowledge for Growth 2026

Event details
Knowledge for Growth is Europe's premier life sciences conference, bringing together industry leaders, innovators, and experts from biotech, pharma, medtech, and beyond. This flagship event offers a dynamic platform to explore the latest trends, groundbreaking research, and key market insights. With inspiring talks, one-on-one partnering opportunities, and a vibrant exhibition, Knowledge for Growth is where the future of life sciences takes shape.
Meet us thereBoost your success in life sciences!
Stop by booth 70 at Knowledge for Growth 2026 and discover how QbD Group can support your life sciences projects.
Explore innovative solutions – Learn how we help companies navigate complex challenges and drive seamless project progression.
Connect with our experts – Get tailored advice from our specialists on regulatory, quality, clinical, and product development strategies.
Access exclusive insights – Stay ahead with expert perspectives on emerging trends and the future of the industry.
Be inspired by success stories – See how our clients have transformed their operations with QbD Group's expertise.
Connect with our team of experts
We invite you to connect with our team during Knowledge for Growth 2026. Whether you're looking to expand into the EU market, seeking regulatory advice, or simply want to learn more about the latest developments in the field, QbD Group is here to help. Get in touch with our team at Knowledge for Growth 2026 or contact us today.
Steven Geelen
Senior Account Manager
Steven Geelen is an accomplished Account Manager at QbD Group, bringing a wealth of experience in talent development and business development within the life sciences sector. Prior to joining QbD Group, Steven served as a Talent Development Manager at Exellys, where he focused on nurturing talent and aligning skills with organizational needs. His career reflects a strong commitment to fostering growth and innovation in the life sciences industry.
Alexander Mahieu
Account Manager
Alexander Mahieu is a self-motivated and success-driven Account Manager at QbD Group, specializing in the pharmaceutical, biotech, ATMP, and medical device sectors. With experience collaborating with both large pharmaceutical companies and SMEs, Alexander engages with key decision-makers across R&D, regulatory, QA/QC, procurement, and C-level roles. He combines his passion for science and innovation with a customer-centric approach to optimize long-term financial value. Open-minded and entrepreneurial, Alexander leverages creativity to address industry challenges effectively.

Ready to accelerate your path to market?
Let our experts help you navigate the complexities of life sciences regulation and quality.
We use cookies to enhance your experience
We use essential cookies for site functionality and optional analytics cookies to improve our services. Read our Privacy Policy and Cookie Policy.